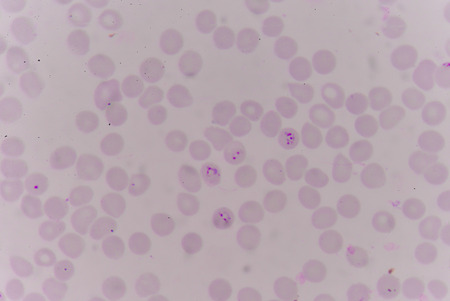
blood films for Malaria parasite.show malaria pigment.の写真素材

写真素材 - blood films for Malaria parasite.show malaria pigment.
キーワード
- Finger
- anopheles
- bfmp
- biology
- blood
- carrier
- close
- coat
- detail
- diagnose
- diagnostic
- disease
- endemic
- epidemic
- falciparum
- filariasis
- film
- glove
- haustellum
- health
- human
- illness
- infectious
- knowlesi
- lab
- laboratory
- malaria
- malariae
- medical
- medicine
- mosquito
- ovale
- pain
- parasite
- parasitic
- paws
- pest
- plasmodium
- ppe
- sample
- sickness
- skin
- slide
- subtropical
- test
- tropical
- unhygienic
- up
- virus
- vivax
類似作品
Malaria blood p...
Malaria blood p...
Malaria parasit...
Red blood cells...
Medicine - Huma...
Immature white...
Red blood cells...
Polycythemia ve...
Blood smear wit...
Trypanosoma gam...
Neutrophil show...
Human blood on ...
microscope lens...
Red blood cells...
Red blood cells...
blood films for...
The malaria-inf...
Immunity. Red b...
Red blood cells...
nucleated red c...
Red blood cells...
Blood cells in ...
Babesia parasit...
Malaria parasit...
plasmodium falc...
nucleated red c...
Red blood cells...
Blood cells in ...
The malaria-inf...
Medical laborat...
illustration of...
Left blood smea...
Trypanosoma lew...
complete blood ...
The malaria-inf...
The malaria-inf...
plasmodium viva...
Red blood cells...
Red blood cells...
Babesia parasit...
Blood smear wit...
Blood group tes...
Cross section o...
Chromosomes Hum...
Human blood cel...
virus ebola and...
The malaria-inf...
Blood smear sho...
The malaria-inf...